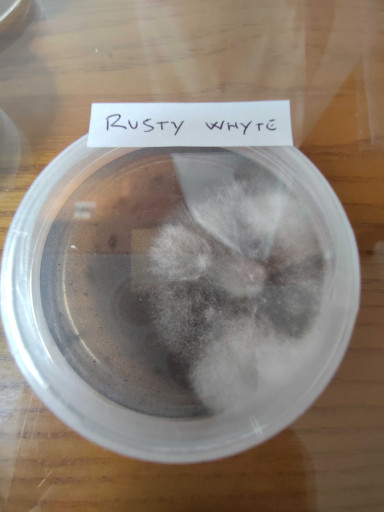
img-20251023-171527.jpg
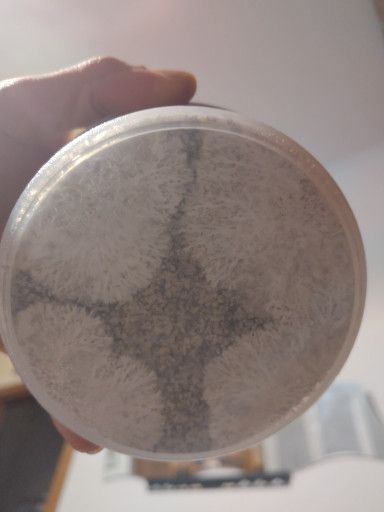
img-20250914-210401.jpg

Vorrei condividere qua gli esperimenti che ho fatto per coltivare Rusty Whyte e McKennaii con la pf-tek, usando una "shotgun box" e buste. Prima volta che provo a coltivare funghi apparte 2 vaschette prefatte, mi sono imbattuto in un po di problematiche impreviste per la mia inesperienza, ma anche soluzioni che condividero sperando che possano essere d'aiuto.
Se qualcuno ha già esperienza con questa tecnica o nel coltivare queste 2 specie, consigli o condivisioni sono ben accetti.
Per i panetti ho usato le proporzioni indicate nella pf-tek di 2:1:1, es. 500ml vermiculite, 250ml farina di riso integrale, 250ml acqua, per 5 "cake" (contenitori da 250ml),
per i rusty whyte ho usato 10 contenitori da 250ml e
per i mkennaii 6 da 500ml,
ho inoculato i rusty whyte il 30/8
mentre i mcKennaii il 5/9,
il 18/9 i rusty whyte erano pronti tutti apparte uno...
i mcKennaii il 26/9 3 erano pronti e 3 no...
Prima problematica, quindi ho messo 9 cake di rusty whyte nel box grande e 3 mcKennaii nel box piccolo, per i ritardatari ho deciso di provare con le buste, come i box prefatti che si comprano, ho riciclato 2 vecchie buste dei box e 2 buste da inoculo.




1° flush:
I rusty whyte un po lenti... sono spuntati il 25/9 e maturati il 3/10 (9gg), c'è da dire che loro sono abbastanza sensibili sia alla luce che alla temperatura ed ho avuto un problema d'umidità, cercando in internet ho capito che era dovuto al fatto che il box è troppo grande per la quantità di cake al suo interno, ho tentato di risolvere mettendo un umidificatore dentro il box, ma nel mentre feci un casino spruzzando troppa acqua che andò a finire sotto le cake portando alcuni funghi quasi a marcire (foto), e ho avuto cambi di temperatura che probabilmente non hanno aiutato perché alla fine primo flush di 9 cake 3 mi hanno fruttificato, 2 poco e una ok, mentre le altre crescita bloccata...solo piccoli funghetti stile primordi.

Nel blu dipinto di blu!

I mcKennaii decisamente più rapidi dopo 2gg messi nel box spuntano il 29/9 e maturano il 4/10 (6gg, li ho tenuti fino al 5 per prendere le spore), che dire buone condizioni sia di umidità che temperatura, temp. 22/25 e umidità 90% circa, penso non ottime di co2 dovuto a un po di "fuzzy feet", ma le cake hanno risposto bene, mi hanno tirato fuori 90g, 85g e 72g con un fungo da 36,5g (foto)


Le 3 buste McKennaii, risultato buono! Ho forzato la crescita verso l'alto mettendo una bustina nera sul fondo per coprire la luce, così è stato, anche se hanno cmq deciso di nascere molti lateralmente e non sulla superfice superiore, ho raccolto 75g, 85g e 88g, come detto sopra un buon risultato ed anche molto pratico ed economico!


Hanno sporato un po...

2° flush:
I McKennaii non hanno perso tempo, dopo averli reidratati per circa 18-20h e rimessi nel box, il giorno dopo già c'erano dei pin...dopo 5gg l'11/10 secondo raccolto, 60g, 55g e 43g (foto)

3° flush:
McKennaii 52g, 45g e 40g il 18/10

Con i Rusty Whyte vari problemi mi hanno bloccato la crescita dei funghi...provero a trovare una soluzione, ma primo esperimento con loro...non è andato proprio bene, però sono riuscito a prendere un impronta sporale per il prossimo tentativo!
Considerazioni:
McKennaii pf-tek ottima
Coltivazione facile, veloci, buon raccolto
Li consiglio vivamente per chi, come me, è principiante e vuole provare la pf-tek!
Rusty Whyte pf-tek non ideale.
Sono una specie particolare, non ho trovato nessuno coltivarli con la pf-tek, tutti in monotub e sembrano dare bei risultati con altri substrati, mi sono scontrato con varie problematiche di temp, umidita, aerazione e anche con il box, questo non mi ha aiutato con la loro coltivazione e sono sicuramente più sensibili dei mckennai, la prossima volta proverò a correggere varie cose e quando avrò occasione riproverò in monotub, vi lascio il link al post del creatore di questa specie, Pasty Whyte, per chi fosse interessato https://www.shroomery.org/forums/showflat.php/Number/25284782
Raccolto:
Utilizzando contenitori da 500ml, equivalenti per contenuto a 2 cake della pf-tek, con 3 flush 175g in media, considerando che il nutrimento all'interno è solo riso integrale che in peso è circa 80g e la vermiculite pesa circa 28g, il BE (biological efficiency) dorebbe essere 160% circa con 3 flush, per essere la mia prima volta sono contento che stia sopra il 100, ma questo conferma che la pf-tek è ottima con i McKennaii!
Origine:
I Mckennaii comprai le spore, che inoculai in una LC di estratto di malto e con l'LC ho inoculato i panetti, mentre i Rusty Whyte comprai un siringa di LC con la quale inoculai direttamente i panetti.
Messi su petri si poteva notare una differenza netta in velocita di colonizazzione della piastra, dove i rusty whyte a confronto sono molto piu lenti e il tipo di micelio molto "tomatose", soffice, mentre i mckennai, secondo me perché multispora appena nati, più veloci e vari tipi di micelio alcuni soffici altri belli rizomorfici.
Nella colonizazzione dei panetti la crescita rizomorfica dei mckennaii si puo vedere bene (foto), e le tempistiche nettamente piu rapide.

Mckennaii

Mckennii
Penso ci siano vari fattori da considerare per ottenere un buon raccolto e partire da un buon micelio è gran parte del lavoro, ma ogni fungo ha delle condizioni che preferisce e dei substrati piu adatti, riproverò con i rusty whyte, ma i mckennaii mi hanno regalato delle belle soddisfazioni!